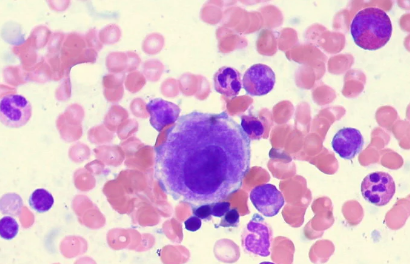

骨髓增生异常综合征 (MDS) 是一种疾病,可发展为急性白血病。它始于骨髓中的干细胞,干扰血细胞的成熟和分化过程。现在赫尔辛基大学的科学家们已经证明,人工智能 (AI) 可以有效地发现 MDS 患者癌细胞中的基因突变。
MDS 是从骨髓样本中诊断出来的,然后对其进行基因变化分析。尽管方法会随着时间的推移而改进,但在某些情况下它们可能并不容易被发现。AI 的最大优势之一是它能够非常快速有效地查看大量数据。这就是为什么科学家们测试它作为一种图像分析技术来筛选 MDS 患者骨髓样本的显微图像。
机器学习算法设法分析了这些样本,并准确识别了影响该综合征进展的最常见基因突变。从本质上讲,人工智能能够在组织样本中看到与 MDS 相关的基因突变。事实上,人工智能可以看到人眼无法看到的特征,从而使诊断更加准确。此外,这种方法有助于跟踪疾病的进展,因为收集细胞变化的定量数据及其与患者预后的相关性变得更加容易。
科学家们认为,这只是人工智能如何使医疗诊断受益的例子之一。它可以帮助选择正确的治疗方法。人工智能可以注意到人眼无法察觉的细节。它可以快速浏览大量数据,发现模式和各种隐藏的细节。在 MDS 的情况下,AI 可以更早地发现癌症,还可以帮助将患者分组以更详细地确定疾病的性质。
参与这项研究的科学家之一奥斯卡·布鲁克 (Oscar Brück) 说:“图像分析帮助我们分析大量活检,并快速生成有关疾病进展的各种信息。该项目中开发的技术也适用于其他项目,它们是数字化医学科学的完美例子。”
骨髓增生异常综合征过去被称为白血病前期或阴燃性白血病。大约三分之一的 MDS 患者会发生癌症。然而,由于出血或感染,经常在没有癌症诊断的情况下死亡。科学家们正在努力开发新的和改进的诊断和治疗方案,但到目前为止,MDS 只能通过骨髓移植在某些情况下治愈。









